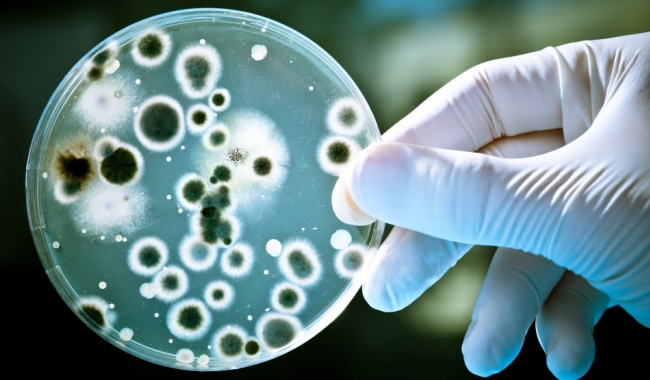

Cercetătorii au descoperit „o verigă lipsă" dintre principalele două forme de viaţă de pe Terra, procariote şi eucariote, care ar putea ajuta la explicarea evoluţiei organismelor cu celule complexe, precum animalele, inclusiv oamenii. Până în prezent, diferenţa dintre celulele simple, precum cele ale microbilor şi bacteriilor, şi cele mai complicate, cum sunt celulele plantelor şi animalelor, a fost considerată atât de mare şi clară încât era dificil de înţeles cum unele au putut evolua din celelalte, potrivit independent.co.uk.
O nouă specie microbiană Totuşi, cercetătorii au descoperit o nouă specie microbiană, care se situează între cele două ramuri ale vieţii şi care pare să fie un descendent al ultimului strămoş comun al ambelor forme de viaţă, cele simple, microbiene, şi cele mai complexe, precum plantele şi animalele. „Am identificat un organism care pare să reprezinte un văr foarte, foarte îndepărtat al nostru, iar acest lucru ne poate oferi informaţii despre trecutul nostru extrem de îndepărtat", a declarat Thijs Ettema, de la Universitatea Uppsala din Suedia, care a condus cercetarea. „Cercetăm originea vieţii complexe care a apărut la puţin timp după apariţia vieţii. Această descoperire pune în lumină nouă originea vieţii complexe", a mai spus Ettema, pentru The Independent.
Lumea ştiinţifică crede că viaţa a apărut pe Terra în urmă cu peste 3,5 miliarde de ani, iar în urmă cu două miliarde de ani, a început să evolueze în două ramuri largi - procariote, precum celulele simple ale bacteriilor, şi eucariote, cu celule complexe, care conţin nuclee şi structuri interne complicate. Potrivit studiului publicat în revista „Nature”, cercetătorii au descoperit un nou organism care are genele ambelor grupe. Organismul a fost descoperit în mostre de sedimente colectate de pe fundul mării, la circa 10 kilometri distanţă de craterul vulcanic subacvatic activ cunoscut drept Loki's Castle, situat în Oceanul Atlantic, între Norvegia şi Groenlanda, la o adâncime de 2.352 de metri.
Noul microb aparţine subgrupului de organisme procariote numit Archaea, dar, în mod unic, posedă şi circa 100 de gene care, până în prezent, au fost văzute doar la organismele eucariote. Aceste gene sunt cunoscute ca având un rol în formarea membranelor şi a structurilor complexe din interiorul celulelor, potrivit lui Ettema.
Genomul complet al organismului, numit formal Lokiarchaeota, dar cunoscut sub numele simplu de „Loki", a fost secvenţiat, permiţându-le cercetătorilor să identifice organismul ca aparţinând unei noi specii. Totuşi, savanţii nu au reuşit încă să cultive acest microb în laborator, în parte din cauză că aceste forme de viaţă care trăiesc la mare adâncime în mediul subacvatic cresc foarte greu, celulele divizându-se o dată la zece ani, potrivit cercetătorului Thijs Ettema.
„Puzzle-ul originii celulei eucariote este unul extrem de complicat, iar multe piese încă lipsesc. Am sperat că Loki va aduce la lumină câteva dintre aceste piese ale puzzle-ului, dar când am obţinut primele rezultate, nu ne-a venit să credem. Datele erau de-a dreptul spectaculoase", a explicat Ettema.
Ultimul strămoş comun al organismelor procariote şi eucariote „Studiind genomul acestui microb, am descoperit că Loki reprezintă o formă intermediară, poziţionată undeva între celulele simple ale microbilor şi cele complexe ale eucariotelor. Este foarte interesant. Aceste gene nu au fost niciodată văzute în afara organismelor eucariote", a continuat cercetătorul. Întrebat dacă cumva Loki reprezintă o verigă simplă dintre cele două mari ramuri ale vieţii, Ettema a spus: „Într-un tip de discurs de popularizare a ştiinţei, am putea spune asta. Dacă analizăm termenul ‘verigă simplă’, atunci Loki este ceva ce trăieşte de foarte mult timp şi este ultimul strămoş comun al organismelor procariote şi eucariote".
Loki este numit după vulcanul subacvatic Castelul lui Loki, care, la rândul său, este numit după zeitatea nordică înşelătoare Loki.
Sursa: mediafax.ro